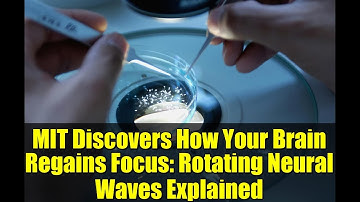
MIT Discovers How Your Brain Regains Focus: Rotating Neural Waves Explained
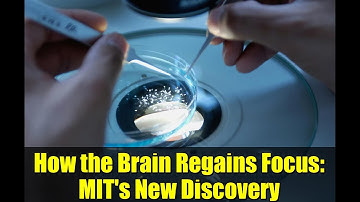
How the Brain Regains Focus: MIT

⬇ DOWNLOAD NOW
Kalau muncul iklan pop-up, tutup lalu klik tombol kembali
Download lagu MIT Discovers How Your Brain Re-Focuses After Distraction (Rotating Brain Waves!) secara gratis hanya untuk keperluan promosi. Dukung artis favorit kamu dengan membeli musik original di iTunes atau platform resmi lainnya.
 MIT Discovers How Your Brain Re-Focuses After Distraction (Rotating Brain Waves!)
MIT Discovers How Your Brain Re-Focuses After Distraction (Rotating Brain Waves!)
 MIT Discovers How Your Brain Regains Focus - Rotating Brain Waves Explained!
MIT Discovers How Your Brain Regains Focus - Rotating Brain Waves Explained!
 How Your Brain Regains Focus After Distractions | MIT Research
How Your Brain Regains Focus After Distractions | MIT Research
MIT Discovers How Your Brain Regains Focus: Rotating Neural Waves Explained
MIT Discovers How Your Brain Regains Focus: Rotating Neural Waves Explained
 MIT Unveils Brain's Focus Mechanism: Rotating Waves Refocus Your Mind
MIT Unveils Brain's Focus Mechanism: Rotating Waves Refocus Your Mind
 Brain's Focus Mechanism UNVEILED! MIT Study Reveals Rotating Neural Waves
Brain's Focus Mechanism UNVEILED! MIT Study Reveals Rotating Neural Waves
 Brain's Amazing Refocusing Trick: MIT Study Reveals Neural 'Herding' Waves
Brain's Amazing Refocusing Trick: MIT Study Reveals Neural 'Herding' Waves
How the Brain Regains Focus: MIT's New Discovery
How the Brain Regains Focus: MIT's New Discovery